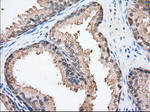
BSG Antibody in Immunohistochemistry (Paraffin) (IHC (P))

Search
OriGene
BSG Monoclonal Antibody (OTI5D8), TrueMAB™
{{$productOrderCtrl.translations['antibody.pdp.commerceCard.promotion.promotions']}}
{{$productOrderCtrl.translations['antibody.pdp.commerceCard.promotion.viewpromo']}}
{{$productOrderCtrl.translations['antibody.pdp.commerceCard.promotion.promocode']}}: {{promo.promoCode}} {{promo.promoTitle}} {{promo.promoDescription}}. {{$productOrderCtrl.translations['antibody.pdp.commerceCard.promotion.learnmore']}}
产品信息
TA501190
种属反应
宿主/亚型
分类
类型
克隆号
抗原
偶联物
形式
浓度
纯化类型
保存液
内含物
保存条件
运输条件
靶标信息
CD147 (basigin, neurothelin, OX-47, 5A11, CE9, M6, EMMPRIN, extracellular matrix metalloproteinase inducer, TCSF, tumour cell-derived collagenase-stimulatory factor) is a 50-60 kDa glycoprotein with multiple glycosylated forms. CD147 is a plasma membrane protein that is important in spermatogenesis, embryo implantation, neural network formation, and tumor progression. CD147 is also a member of the immunoglobulin superfamily. The highest level of CD147 expression is on metabolically active cells, such as lymphoblasts, inflammatory cells, brown adipocytes and malignant tumor cells. CD147 has multiple functions, including facilitating of cell surface expression of monocarboxylate transporter proteins and extracellular matrix metalloproteinases, regulation of integrin functions, it plays roles in cell development and activation, fetal development or retinal function.
仅用于科研。不用于诊断过程。未经明确授权不得转售。
篇参考文献 (0)
生物信息学
蛋白别名: 5F7; Basigin; CD147; Collagenase stimulatory factor; EMMPRIN; Extracellular matrix metalloproteinase inducer; HAb18G; Hepatoma-associated antigen; Leukocyte activation antigen M6; OK blood group antigen; TCSF; Tumor cell-derived collagenase stimulatory factor
基因别名: 5F7; BSG; CD147; EMMPRIN; OK; TCSF; UNQ6505/PRO21383
UniProt ID: (Human) P35613
Entrez Gene ID: (Human) 682